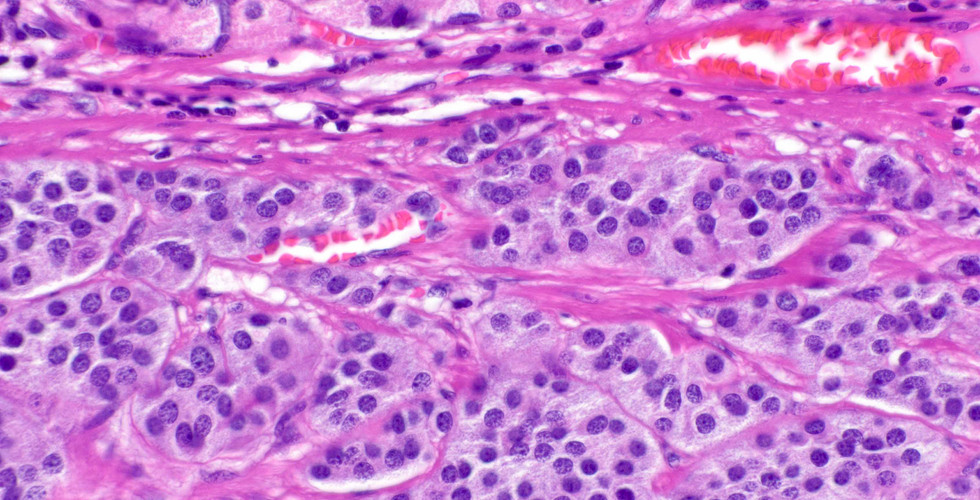

Case of the Week
- Elizabeth Montgomery, MD
- Jan 15, 2023
- 1 min read
Well differentiated neuroendocrine (carcinoid) tumor, the old Type 3, arising in normal oxyntic mucosa, which is more aggressive than those associated with autoimmune gastritis (Type 1). However, a pitfall on mucosal biopsies is that mucosa on top of the lesion can display atrophic features. This is yet another reason to remind our endoscopy colleagues to be in the habit of sampling flat mucosa around gastric lesions.
Case provided by Dr. Elizabeth Montgomery, Clinical Professor, Vice Chair of Faculty Development & Mentoring, Director of Surgical Pathology Fellowship Training Program, Co-Director, Pathology Reference Services, and Editor-In-Chief at Innovative Science Press.
You can check out our titles at:
info@innovativepathologypress.com
1-703-350-4308/703-340-3198
Fax: 1-855-661-7331

Comments